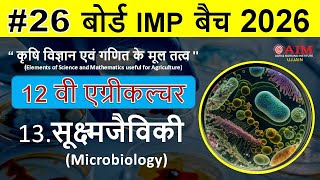

Shared 1 week ago
4.1K views
Shared 2 weeks ago
74 views
Shared 1 month ago
1.5K views
Shared 1 week ago
4.9K views
Shared 1 week ago
7.6K views
MP Board Class 12 Agriculture Chapter 1 |जल निकास (Drainage) Full Solution + PDF |Fasal Utpadan 2025
Shared 6 months ago
150 views
Shared 4 weeks ago
193 views
Shared 3 weeks ago
56 views
Shared 3 days ago
675 views
Shared 1 month ago
157 views
Shared 1 month ago
53 views
Shared 5 months ago
534 views
Shared 5 months ago
32 views
MP Board Class 11 Agriculture | Chapter 1 प्रकाश (Light)| PCMB Notes + PDF | Class 11th Science #RMS
Shared 6 months ago
503 views
Shared 1 month ago
136 views
Shared 2 days ago
1K views
Shared 1 week ago
320 views
Insects of Agriculture Part–2 | Class12th Agriculture | MP Board & PAT Objective Questions | RAY Sir
Shared 1 month ago
128 views